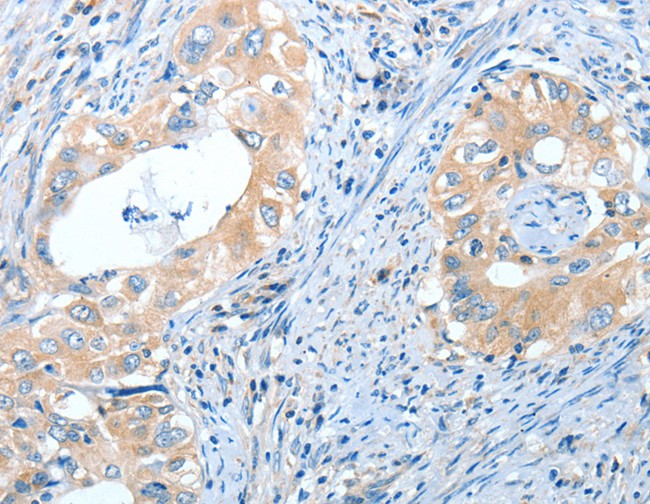
product-image-AAA169660_IHC13.jpg

IL13RA2 recombinant protein
IL13RA2, 27-343aa, Human, hIgG-His-tag, Baculovirus
For long term storage, aliquot and store at -20 degree C or -80 degree C.
Avoid repeated freezing and thawing cycles.
NCBI and Uniprot Product Information
Customer Reviews
Loading reviews...
Share Your Experience
Similar Products
Product Notes
The IL13RA2 il13ra2 (Catalog #AAA11835) is a Recombinant Protein produced from Baculovirus and is intended for research purposes only. The product is available for immediate purchase. The tag for this protein is hIgG-His-tag!!Domain||27-343aa. AAA Biotech's IL13RA2 can be used in a range of immunoassay formats including, but not limited to, SDS-PAGE. Researchers should empirically determine the suitability of the IL13RA2 il13ra2 for an application not listed in the data sheet. Researchers commonly develop new applications and it is an integral, important part of the investigative research process. The amino acid sequence is listed below: ADLDTEIKVN PPQDFEIVDP GYLGYLYLQW QPPLSLDHFK ECTVEYELKY RNIGSETWKT IITKNLHYKD GFDLNKGIEA KIHTLLPWQC TNGSEVQSSW AETTYWISPQ GIPETKVQDM DCVYYNWQYL LCSWKPGIGV LLDTNYNLFY WYEGLDHALQ CVDYIKADGQ NIGCRFPYLE ASDYKDFYIC VNGSSENKPI RSSYFTFQLQ NIVKPLPPVY LTFTRESSCE IKLKWSIPLG PIPARCFDYE IEIREDDTTL VTATVENETY TLKTTNETRQ LCFVVRSKVN IYCSDDGIWS EWSDKQCWEG EDLSKKTLLR LEPKSCDKTH TCPPCPAPEL LGGPSVFLFP PKPKDTLMIS RTPEVTCVVV DVSHEDPEVK FNWYVDGVEV HNAKTKPREE QYNSTYRVVS VLTVLHQDWL NGKEYKCKVS NKALPAPIEK TISKAKGQPR EPQVYTLPPS RDELTKNQVS LTCLVKGFYP SDIAVEWESN GQPENNYKTT PPVLDSDGSF FLYSKLTVDK SRWQQGNVFS CSVMHEALHN HYTQKSLSLS PGKHHHHHH. It is sometimes possible for the material contained within the vial of "IL13RA2, Recombinant Protein" to become dispersed throughout the inside of the vial, particularly around the seal of said vial, during shipment and storage. We always suggest centrifuging these vials to consolidate all of the liquid away from the lid and to the bottom of the vial prior to opening. Please be advised that certain products may require dry ice for shipping and that, if this is the case, an additional dry ice fee may also be required.Precautions
All products in the AAA Biotech catalog are strictly for research-use only, and are absolutely not suitable for use in any sort of medical, therapeutic, prophylactic, in-vivo, or diagnostic capacity. By purchasing a product from AAA Biotech, you are explicitly certifying that said products will be properly tested and used in line with industry standard. AAA Biotech and its authorized distribution partners reserve the right to refuse to fulfill any order if we have any indication that a purchaser may be intending to use a product outside of our accepted criteria.Disclaimer
Though we do strive to guarantee the information represented in this datasheet, AAA Biotech cannot be held responsible for any oversights or imprecisions. AAA Biotech reserves the right to adjust any aspect of this datasheet at any time and without notice. It is the responsibility of the customer to inform AAA Biotech of any product performance issues observed or experienced within 30 days of receipt of said product. To see additional details on this or any of our other policies, please see our Terms & Conditions page.Frequently Asked Questions
What applications is the IL13RA2 recombinant protein commonly used for?
IL13RA2 recombinant protein is widely used in cancer research, cell-based assays, and immunotherapy studies. It serves as a ligand for receptor binding assays, CAR-T cell engineering validation, and functional studies related to IL-13 signaling modulation in tumor microenvironments.
What is the recommended working concentration for cell-based assays?
Typical working concentrations range from 0.1 to 10 µg/mL, depending on the specific assay. AAA Biotech generally recommends empirically determining optimal concentrations for individual applications through titration studies.
How should the IL13RA2 protein be reconstituted?
Reconstitute with sterile PBS or cell culture-grade water. Avoid vortexing; gently mix by inversion. Allow 15-30 minutes at room temperature for complete dissolution. Prepare aliquots to minimize freeze-thaw cycles.
What storage conditions are required to maintain protein stability?
Store at -80°C in aliquots for long-term stability. Short-term storage (up to 2 weeks) is acceptable at 2-8°C. Avoid repeated freeze-thaw cycles. Lyophilized preparations should be stored desiccated at -20°C or lower.
Is the recombinant IL13RA2 tested for purity and bioactivity?
Yes, AAA Biotech's recombinant proteins undergo affinity purification and are validated for bioactivity through ELISA and cell-based assays to confirm receptor binding functionality.
What endotoxin level is provided for this IL13RA2 preparation?
AAA Biotech maintains endotoxin levels below 1.0 EU/µg for research-grade proteins, ensuring suitability for cell culture and immunological applications.
Item has been added to Shopping Cart
If you are ready to order, navigate to Shopping Cart and get ready to checkout.